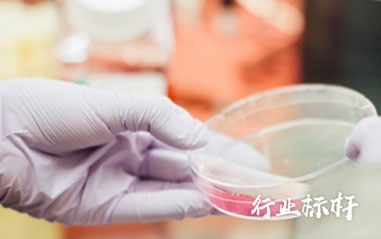

咨詢熱線 

- 網(wǎng)站首頁
-
產(chǎn)品中心
 產(chǎn)品中心
產(chǎn)品中心
-
面向中大型企業(yè)
-
面向中小型企業(yè)
-
云產(chǎn)品
-
開發(fā)平臺
-
專業(yè)應用領(lǐng)域
-
-
解決方案
 解決方案
解決方案
- 實施服務
- 客戶案例
- 資源中心
- 在線試用
- 關(guān)于我們